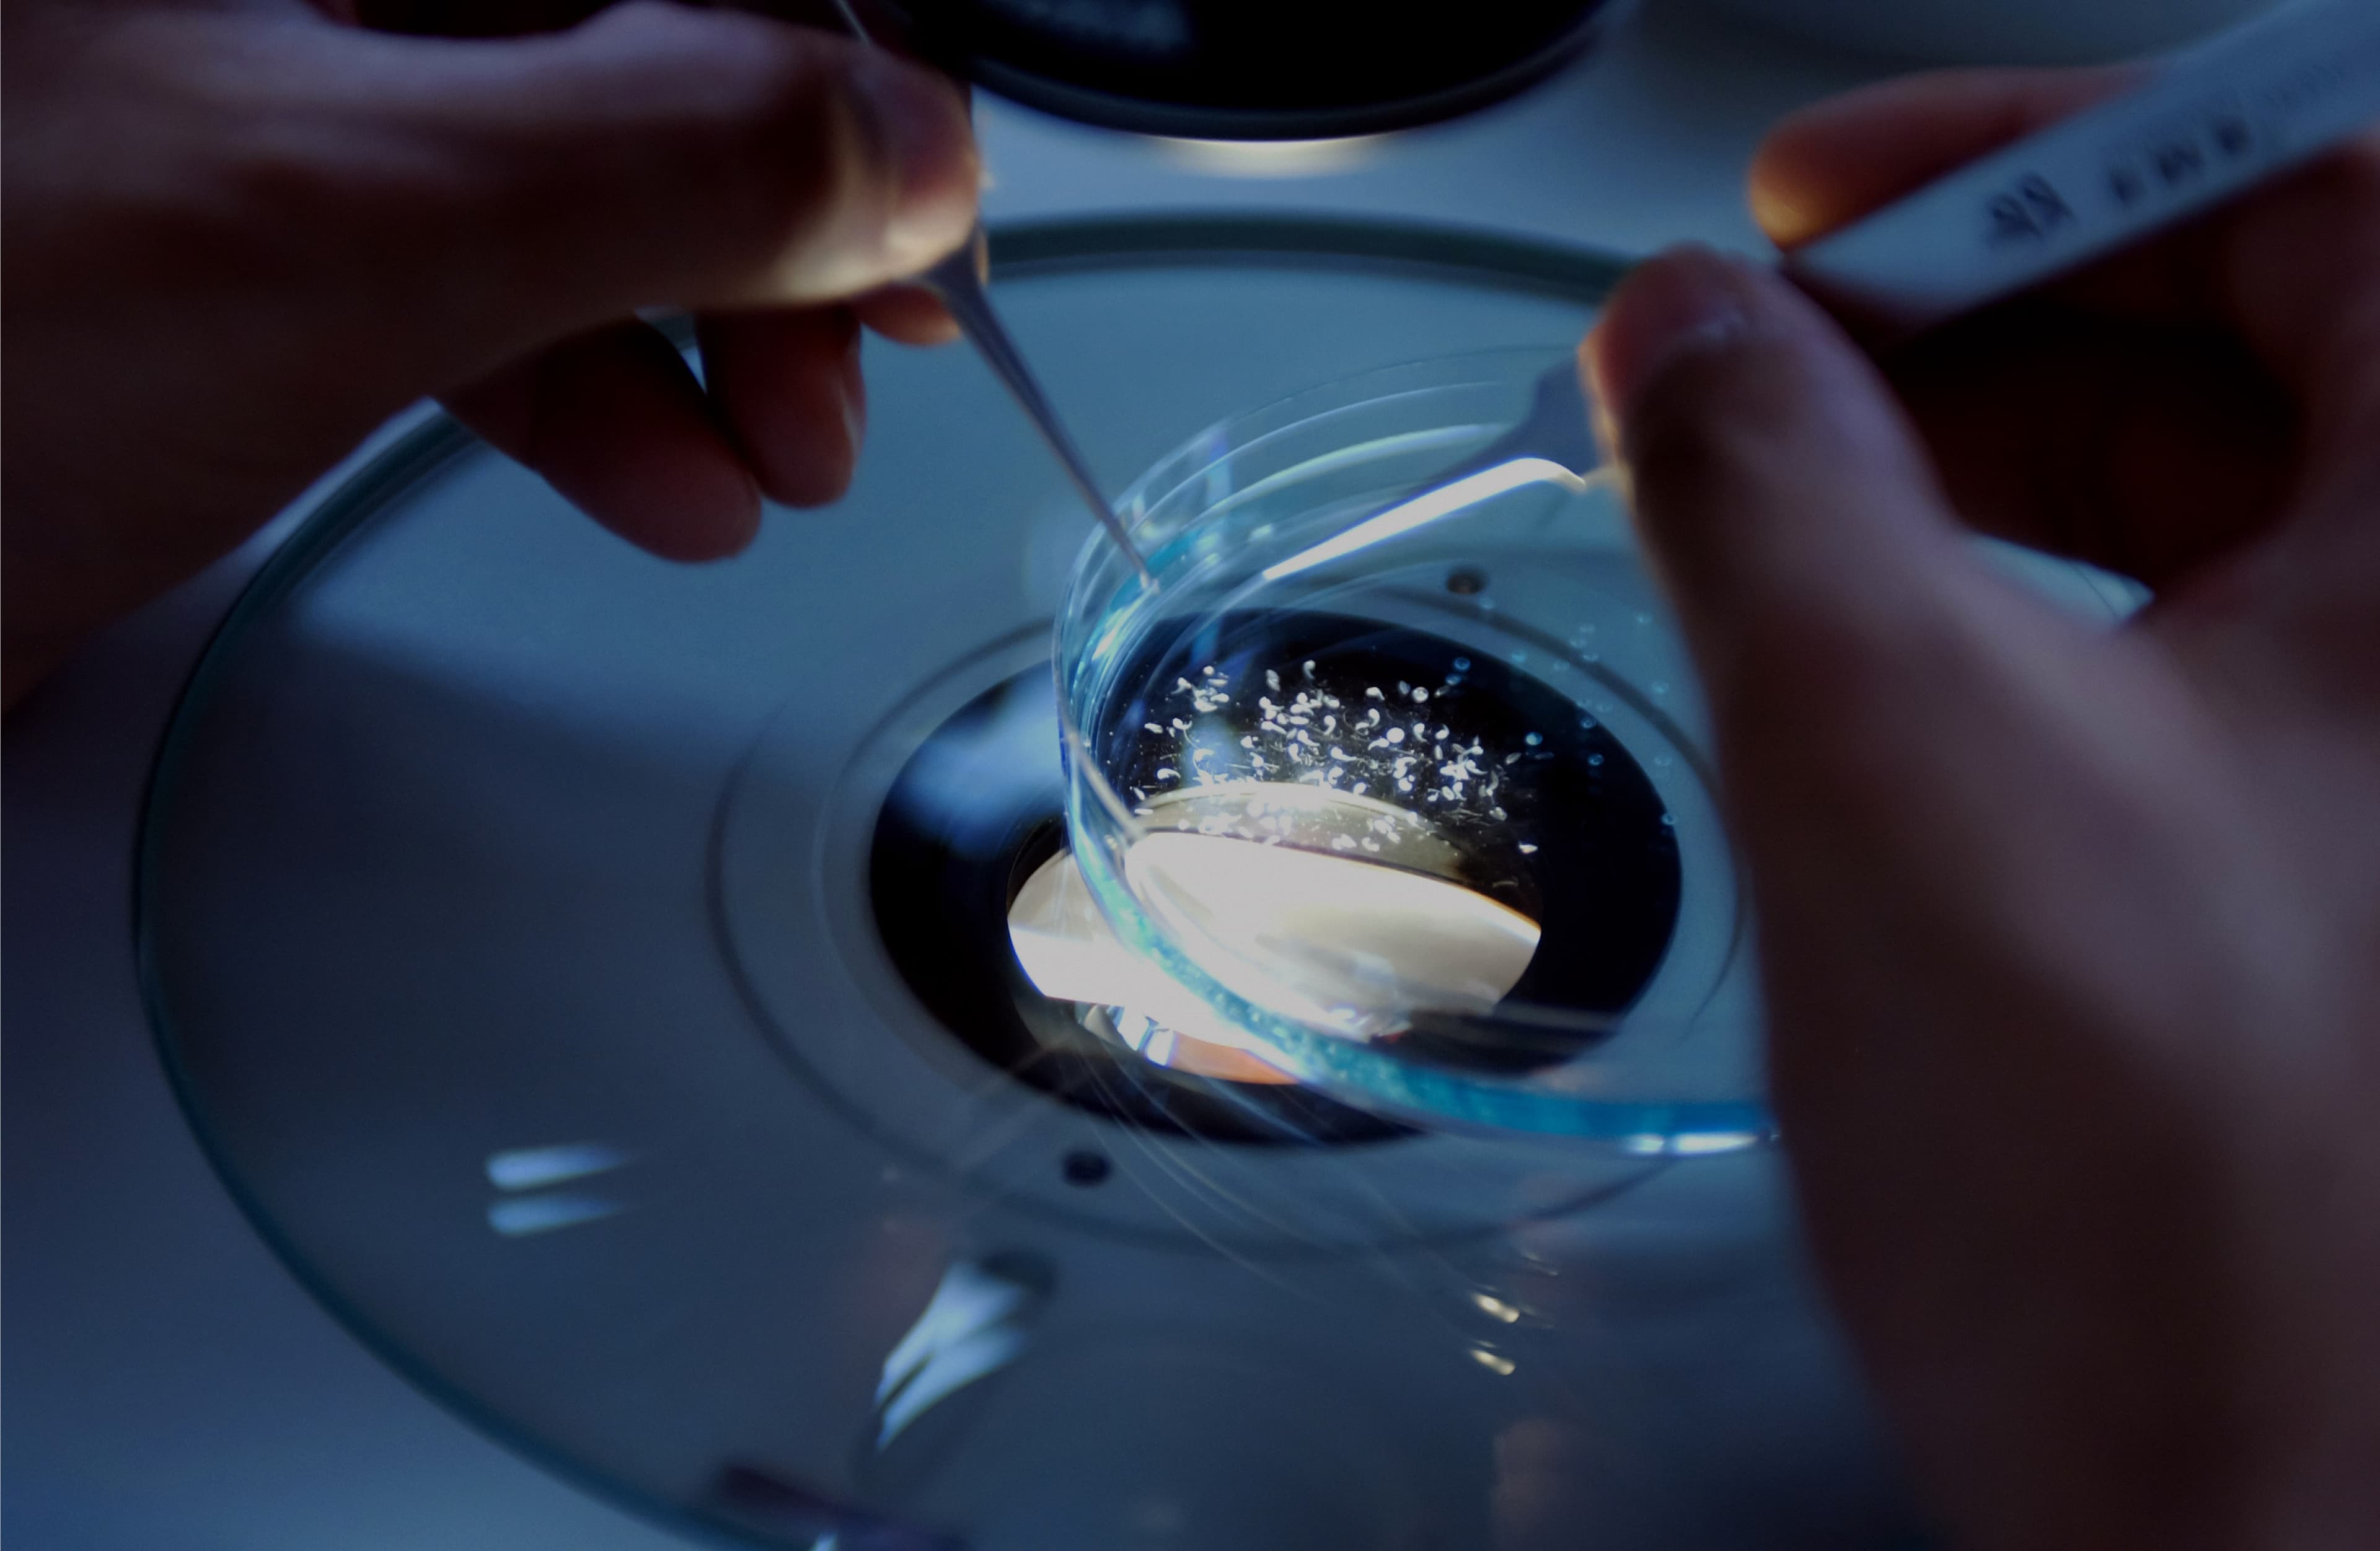

Type 1 Diabetes
NICHE, our subcutaneously implantable platform, is designed to implant insulin-producing cells into the body and provide a locally immuno-protected environment that supports their extended survival.

Continuity Biosciences is built on a simple idea: Therapeutic potential should be amplified through precision delivery. By combining advanced engineering with deep biological insights, we develop adaptive delivery platforms that guide promising therapies, from small molecules to biologics and cell-based treatments, exactly where they are needed. Merging medtech and biotech to achieve what neither can alone.
Reach out to explore how our delivery technology works.
Multiple platforms, one purpose:
Delivering treatment precisely where it matters most.
This strategic investment will accelerate development of NICHE, our 3D-printed implantable platform advancing precision delivery for Type 1 diabetes. Designed to implant insulin-producing cells into the body, NICHE creates a protected, vascularized environment that supports their survival and function while reducing the need for whole-body immune suppression.